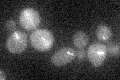
YMR198W
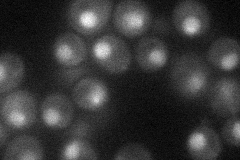
YMR198W
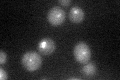
YMR198W
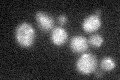
YMR198W

View description
Kinesin-associated protein required for both karyogamy and mitotic spindle organization, interacts stably and specifically with Kar3p and may function to target this kinesin to a specific cellular role; has similarity to Vik1p
Localization:
Intensity:
Fold change:
Significance:
-
C’ GFP library in SD
punctate19.79 -
N' NOP1pr-GFP in SD
nucleus30.6165 -
N' TEF2pr-mCherry in SD

nucleus11.597 -
N' NATIVEpr-GFP in SD

punctate20.5999 -
N' TEF2pr-VC and Cyto-VN in SD

below threshold24.8335 -
C’ GFP library in SD+DTT
punctate18.050.91No -
C’ GFP library in SD+H2O2
punctate18.830.95No -
C’ GFP library in Starvation Media

punctate14.450.72No -
C’ GFP library on the background of Pup2-DaMP

punctate -
C’ GFP library on the background of CCT mutant

punctate21.81391.10187No
